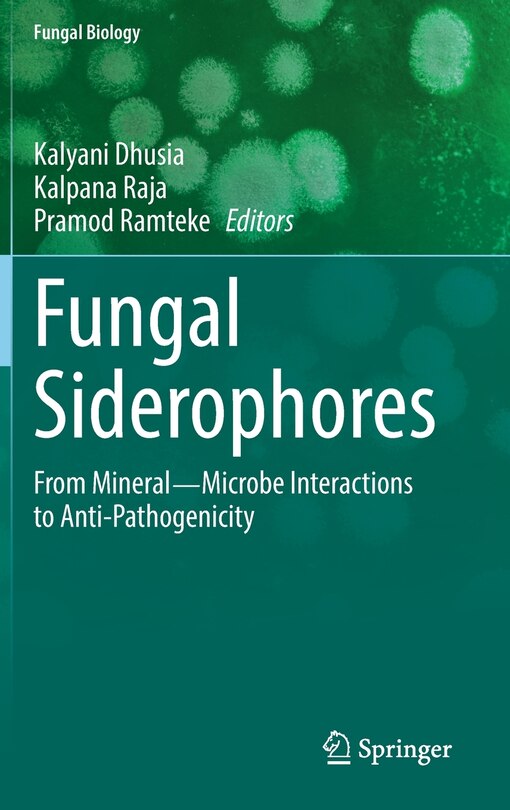
Couverture_Fungal Siderophores

Aperçu gratuit du livre Fungal Siderophores: From Mineral-microbe Interactions To Anti-pathogenicity
291,95 $
Prix en ligne. Les prix et les offres peuvent différer en magasin.

M’expédier cet article
Vérification des stocks…
Acheter maintenant et ramasser en magasin
Vérification des stocks…
Trouver en magasin
Vérification des stocks…
Description
Publié par: Springer Nature
Dimensions à l’expédition: 9" H x 6" W x 1" L
ISBN: 9783030530761
Étape de vie: null
Cotes et évaluations
D’autres ont aussi acheté
Fungal Siderophores: From Mineral-microbe Interactions To Anti-pathogenicity
/fr-ca/fungal-siderophores-from-mineral-microbe-interactions-to-anti-pathogenicity/6A4AFD52-5562-4A1D-9234-F58FC8CF6F2E.html
6A4AFD52-5562-4A1D-9234-F58FC8CF6F2E
Fungal Siderophores: From Mineral-microbe Interactions To Anti-pathogenicity
https://dynamic.indigoimages.ca/v1/books/books/3030530760/1.jpg
291.95
Fungal Siderophores: From Mineral―Microbe Interactions to Anti-Pathogenicity
https://dynamic.indigoimages.ca/v1/https://cdn.kobo.com/book-images/Images/5a752954-afab-4495-ac5b-ebbd73179dea/300/300/False/image.jpg
262.15